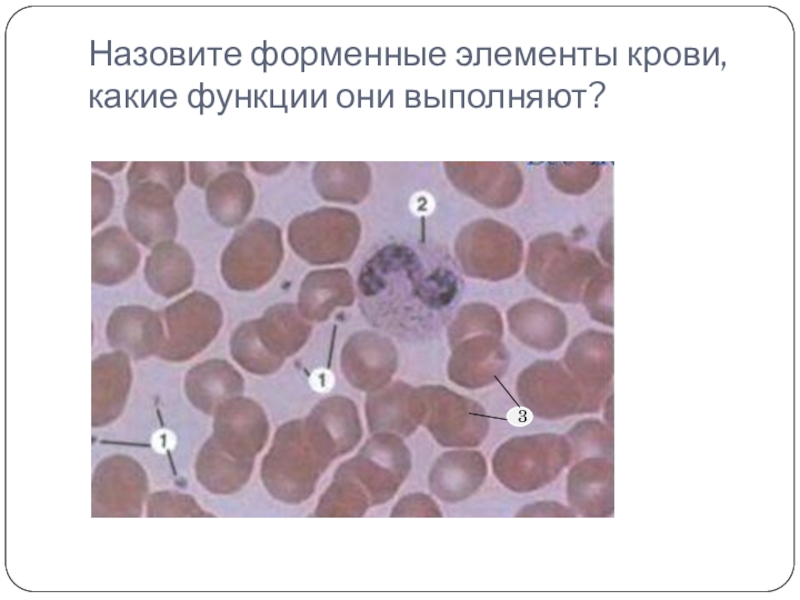

- Главная
- Разное
- Образование
- Спорт
- Естествознание
- Природоведение
- Религиоведение
- Французский язык
- Черчение
- Английский язык
- Астрономия
- Алгебра
- Биология
- География
- Геометрия
- Детские презентации
- Информатика
- История
- Литература
- Математика
- Музыка
- МХК
- Немецкий язык
- ОБЖ
- Обществознание
- Окружающий мир
- Педагогика
- Русский язык
- Технология
- Физика
- Философия
- Химия
- Шаблоны, фоны, картинки для презентаций
- Экология
- Экономика
Презентация, доклад к уроку биологии Нервные клетки – живые провода
Содержание
- 1. Презентация к уроку биологии Нервные клетки – живые провода
- 2. Озвучьте рисунокЛегочные капиллярыАортаКапилляры большого кругаАртериоллыВоротная вена печениКапилляры печениНижняя полая венаЛимфатические протокиЛегочная артерияВерхняя полая венаКапилляры головного мозга
- 3. Назовите форменные элементы крови, какие функции они выполняют?3
- 4. Как согласовать работу всех систем?1.Вы опаздываете на
- 5. Учитель биологии МБОУ СОШ № 70 г.ЛипецкаАленина Е.А.Нервные клетки – «живые провода»
- 6. Способы регуляции организма
- 7. Как устроен нейрон?Тело(сома) нейронаДендритАксон Нервные окончания нейронаСерое
- 8. Что такое синапс?Что такое нейромедиатор?Какое влияние они
- 9. Торможение или возбуждение преобладало у этих человечков
Озвучьте рисунокЛегочные капиллярыАортаКапилляры большого кругаАртериоллыВоротная вена печениКапилляры печениНижняя полая венаЛимфатические протокиЛегочная артерияВерхняя полая венаКапилляры головного мозга
Слайд 2Озвучьте рисунок
Легочные капилляры
Аорта
Капилляры большого круга
Артериоллы
Воротная вена печени
Капилляры печени
Нижняя полая вена
Лимфатические протоки
Легочная
артерия
Верхняя полая вена
Капилляры головного мозга
Верхняя полая вена
Капилляры головного мозга
Слайд 4Как согласовать работу всех систем?
1.Вы опаздываете на важную встречу, Очень спешите,
переходите на бег? Какие изменения произойдут в вашем организме?
2. Люди в путешествиях часто страдают от морской болезни. Что это за болезнь и почему она возникает?
2. Люди в путешествиях часто страдают от морской болезни. Что это за болезнь и почему она возникает?
Слайд 7Как устроен нейрон?
Тело(сома) нейрона
Дендрит
Аксон
Нервные окончания нейрона
Серое вещество НС
Белое вещество НС
Миелиновая
оболочка нейрона: чем она образована и в чем ее функция?
Слайд 8Что такое синапс?
Что такое нейромедиатор?
Какое влияние они могут оказывать на клетки?
Как
можно использовать знания работе нейромедиаторов?
Быстро реакции спортсмена – залог его побед. Что является главным ограничителем скорости его реакции: движение сигнала по нейрона или передача через синапс?
Придумайте примеры ситуаций, регулируемых процессами возбуждения и торможения
Быстро реакции спортсмена – залог его побед. Что является главным ограничителем скорости его реакции: движение сигнала по нейрона или передача через синапс?
Придумайте примеры ситуаций, регулируемых процессами возбуждения и торможения
Слайд 9Торможение или возбуждение преобладало у этих человечков в то время, когда
задавалось домашнее задание?
Домашнее задание
§ 15, вопросы 1-6